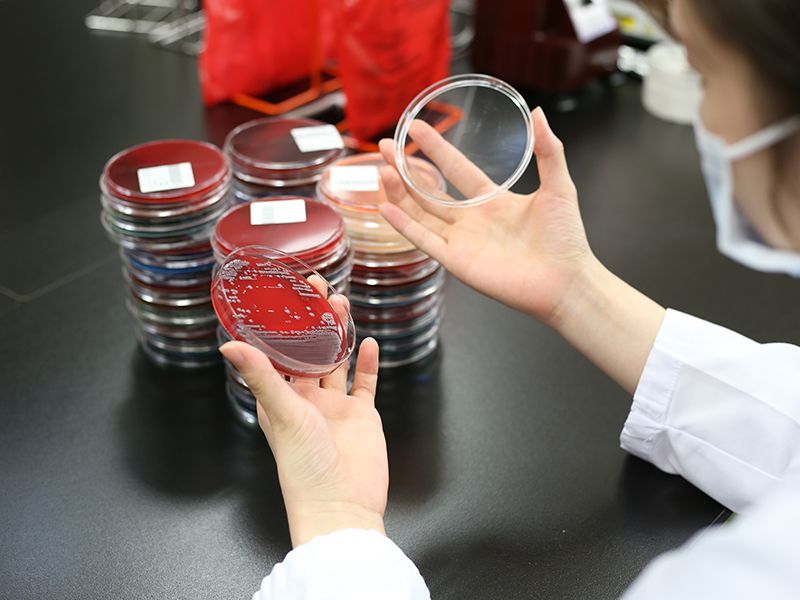
臨床検査部による検査中の様子。

臨床検査部
臨床検査部の概要
スタッフ紹介(2025年1月現在)
臨床検査部長 鈴木理(すずきおさむ)
臨床検査技師 21名(うち准職員と非常勤職員3名)
事務職員 3名
特徴・特色
- 1.緊急性の高い検査について、24時間対応可能な体制
- 2.受診前採血・採尿に対し、迅速な結果報告
- 3.内部精度管理の徹底、および外部精度管理事業に積極的に参加し、正確で精度の高い検査データの提供を目指す
- 4.院内感染対策チーム(ICT)、栄養サポートチーム(NST)、褥瘡予防チームなど各種院内チームへの参画
- 5.定期的に検査機器更新を行い、検査のさらなる迅速化を目指す
- 6.活発な学術活動および個人研鑽を通し、各々が資質の向上に努める
- 7.日本輸血・細胞治療学会輸血機構評価認定制度(I&A制度)2024年取得済
認定資格(2025年1月現在)
- タスク・シフト/シェアに関する厚生労働大臣指定講習会修了者: 19名
- 緊急臨床検査士(日本臨床検査同学院): 3名
- 救急検査認定技師(日本臨床救急医学会): 1名
- 細胞検査士(日本臨床細胞学会): 1名
- 認定輸血検査技師(日本輸血・細胞治療学会): 2名
- 認定病理検査技師(日本病理学会): 1名
- 認定血液検査技師(日本検査血液学会): 2名
- 認定心電検査技師(日本臨床衛生検査技師会): 1名
- JHRS認定心電図専門士(日本不整脈心電学会): 1名
- 超音波検査士(日本超音波医学会): 4名
- 脳波分野専門技術師(日本臨床神経生理学会): 1名
- 筋電図・神経分野専門技術師(日本臨床神経生理学会): 1名
- 日本糖尿病療養指導士(日本糖尿病療養指導士会): 2名
- 福島県糖尿病療養指導士(福島県糖尿病療養指導士会): 3名
- 特定化学物質及び四アルキル鉛等作業主任者(県労働基準協会): 4名
- 福島県肝炎医療コーディネーター(福島県): 5名
残余検体の二次利用について
福島県立医科大学会津医療センター附属病院臨床検査部では、信頼性の高い検査データを提供するために日々精度管理を実施しています。また、大学病院として病態の解明や検査異常値の解析などの研究を行っています。これらの精度管理や研究活動を行う上で、患者さんの診療のために採取させていただいた検体のうち、残った検体(血液や尿、組織など、以下「残余検体」とします)が生じた場合にはそのうちの一部を検査の精度管理、診断の精度向上などを目的として適時利用させていただいております。
日本臨床検査医学会の「臨床検査を終了した既存試料(残余検体)の研究、業務、教育のための使用について」を遵守し、福島県立医科大学倫理委員会承認のもとに残余検体や検査データの再利用(二次利用)を行っています。
検査終了後に廃棄する残余検体および検査データを使用するため、患者さんの生命や健康に影響を及ぼすことはなく、また、氏名・生年月日・住所・電話番号・ID番号などの個人情報はすべて匿名化された状態で解析を行うため、個人が特定されたり情報が漏れたりすることはありません。研究対象に該当しない場合でも、診療や治療に影響することはありませんし、研究にご協力いただけない場合でも不利益を受けることはありません。
検査終了後の残余検体や検査データの再利用(二次利用)にご承諾いただけない患者さんは、お手数ですが、検査時に担当者までお申し出ください。
業務内容
私たち臨床検査部では、患者さんの病気の診断・治療方針の決定や治療効果を判定するために必要な多くの検査情報を正確・迅速に提供しています。
臨床検査は、患者さんの体に直接触れて行う「生理機能検査」と患者さんから取り出した材料(検体)で行う「検体検査」に大別されます。
「生理機能検査」には、心電図や脳波検査のようにヒトの微細な電気信号を捉える電気生理検査や超音波診断装置を使用して臓器の大きさ・形・血流などを計測する画像検査などがあります。
また「検体検査」は血液・尿などに含まれる微量物質や細胞の分析、輸血のための検査、細菌やウイルスの検査、組織や細胞を顕微鏡で見る検査などがあります。
検査の種類
生理機能検査
心電図検査、呼吸機能検査、脳波検査、血管検査、心臓・腹部超音波検査
検体検査
尿一般検査(尿、糞便、体液)、血液検査(血球算定、血液像、凝固・線溶検査、骨髄像)、輸血検査(血液型、抗体スクリーニング、クロスマッチ)、生化学・免疫血清検査、細菌検査(一般細菌、抗酸菌の塗沫・培養・同定・薬剤感受性検査)、病理検査(病理組織検査、細胞診検査、病理標本作成、免疫染色、病理解剖)
夜間・休日の緊急検査
オンコール体制による、血液検査、生化学検査等の緊急検査項目と輸血検査への対応

主な検査機器、設備
臨床検査部では、安全で効率的な検査部の運営・ 管理を実現する「臨床検査情報システム」を採用しております。
| 尿一般検査部門 | 尿定性・沈渣分析装置 |
|---|---|
| 血液・輸血検査部門 | 血球計数・標本作成装置、血液像分析装置、凝固・線溶分析装置、輸血検査分析装置 |
| 生化学・免疫血清検査部門 | 生化学分析装置+ 免疫分析装置+ 検体分注搬送システム、血糖/HbA1c 分析装置、血液ガス分析装置 |
| 細菌検査部門 | 一般細菌同定/ 薬剤感受性検査装置、血液培養装置、抗酸菌培養装置、自動核酸増幅/検出装置 |
| 生理検査部 | 心電計、血圧・脈波装置、呼吸機能検査装置、脳波計、ホルター心電図解析装置、超音波検査装置 |
| 病理検査部門 | 凍結切片作成装置、自動固定包埋装置、自動免疫染色装置、自動染色装置+ 封入装置 |
